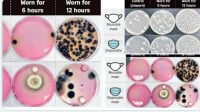

Pandemi Covid-19 terus meningkat dengan keadaan yang makin banyak terpapar kasus positif Covid-19. Menurut data dari worldometers.info. total kasus Covid-19 Selengkapnya
Headlines
Tag: Masker
Mahasiswa KKN UIN Walisongo Berbagi 150 Masker dan Hand Sanitizer
Semarang–Kelompok 2 Kuliah Kerja Nyata Dari Rumah (KKN MIT DR) angkatan 12 UIN Walisongo mengadakan kegiatan berbagi masker dan hand Selengkapnya
Ngeri! Ini Penampakan Mikroba Jika Tak Ganti Masker Lebih dari 6 Jam
Masker menjadi benda yang wajib dipakai di masa pandemi Covid-19. Karena diyakini bisa mencegah penularan virus sampai 90 persen. Dengan Selengkapnya
2 Penimbun Masker dan Hand Sanitizer di Semarang Ditangkap
Subdit Jatanras Polda Jawa Tengah menangkap dua orang penimbun masker dan hand sanitizer di Kota Semarang, Selasa (3/3). Mereka diduga Selengkapnya
Tidak Ada Pos Lagi.
Tidak ada laman yang di load.